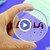
Вижте, реакцията на дете разбрало, че е болно от ебола

Николай Слатински: Изказването на ген. Мутафчийски е абсолютно глупаво
- Редактор: Петър Симеонов
- Коментари: 0

Може да съм си загубил чувството за хумор, но е абсолютно глупаво изказването на ген. Мутафчийски, че първите ваксинирали се са пингвини, които били скочили
Не може за толкова сериозни неща да се говори по толкова несериозен, направо идиотски в случая начин. За ваксините днес си е почти като за БСП и СДС някога – разделителните линии минават през семейства, през роднинства, през приятелства, през познанства, през душите на хората. Друг е въпросът, че аз не виждам друго решение на проблема с пандемията освен ваксините.
Всяка ваксина срещу смъртоносна болест е пораждала през последните век и половина безумни спорове и мнозина са платили с живота си за това, че са заемали крайна отрицателна позиция. Инатът никога не е спирал прогреса, обаче е правил пробиването на пътя му много по-трудно и на далеч по-висока цена.
Но моето лично мнение за ваксинирането днес си е мое лично мнение. То никого не ангажира и никого не принуждава да го споделя.
Ала отговорните хора, в смисъл хората с отговорности, не могат да говорят за този тежък и сложен проблем безотговорно и лековато, та дори и да се опитват да ни демонстрират многократно доказаното, че им липсва, чувство за хумор!
Николай Слатински, Фейсбук

Учители готвят ефективна национална стачка
Георги Кандев: Напускам МВР
Слави Трифонов: Господин Демерджиев, няма да спра да Ви...
Слави Трифонов: Господин Демерджиев, няма да спра да Ви...
Учители готвят ефективна национална стачка